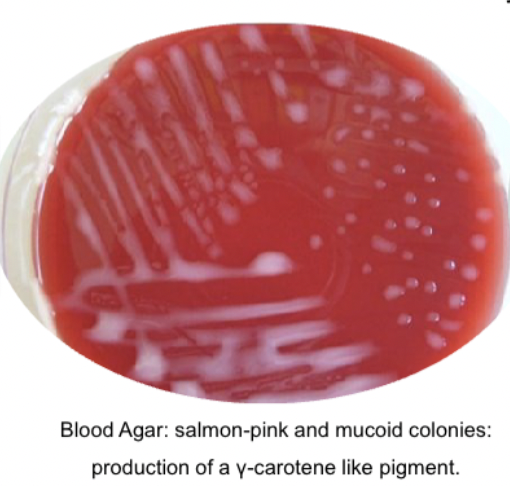
<p>Pink mucoid colonies on blood agar, non hemolytic </p>

1/103
Looks like no tags are added yet.
Name | Mastery | Learn | Test | Matching | Spaced |
|---|
No study sessions yet.
What form of dermatophyte
Macroconidia on cultures
Arthrospores infectious forms
What is caused by dermatophytes
Dermatophytosis
What does dermatophytosis cause
Circular alopecic lesions, erythema, scaling

What type of conidia in aspergillus spp
Phialoconidia
What is caused by aspergillus fumigatus
guttural pouch mycosis
What clinical signs of guttural pouch mycosis
Epistaxis, dysphagua, laryngeal hemiplegia
What fungus is candida albicans
Yeast
What morphology of candida albicans
polymorphic

Main virulence factor candida albicans
Phenotypic switching
What kind of fungus is cryptococcus neoformans
Yeast
Morphology of cryptococcus neoformans
Round to oval budding cells

Main virulence factor of cryptococcus neoformans
Capsule and phenol oxidase
What kind of fungus is malassezia pachydermatis
yeast
Morphology malassezia
Shoe shaped

Clinical signs of candida albicans
Lesions in oral cavity, GI tract, urogenital tract, cutaneous lesions…

Clinical signs cryptococcus neoformans
Nasal swelling, CNS signs, nasal granulomas, cutaneous lesions, pneumonia

Clinical signs of malassezia pachydermatis
Otitis externa, seborrheic dermatitis, acne…
What kind of fungus is blastomyces dermatidis
Dimorphic fungus
Mould form and yeast form of blastomyces dermatitis
Mould - septate hyphae with conidia
Yeast - broad based budding cells

Clinical signs of blastomyces dermatitidis
Chronic cough, fever, weight loss, draining skin lesions, ocular lesions
What kind of fungus is histoplasma capsulatum
Dimorphic fungus
Mould and yeast form of histoplasma capsulatum
Mould - septate hyphae with small conidia and sunflower macroconidia
Yeast - small oval budding yeast cells in macrophages

Clinical signs of histoplasma capsulatum
Chronic cough, dyspnea, depression, fever, loss of weight, diarrhea, intestinal ulcers
What special cytology feature would you see in histoplasma capsulatum
Macrophages with yeast cells with halos

What kind of fungus is histoplasma farciminosum
Dirmophic fungus
Mould and yeast form of histoplasma farciminosum
Mould - septate hyphae with small conidia and sunflower macroconidia
Yeast - small oval budding yeast cells in macrophages

Clinical signs of histoplasma farciminosum
Swelling and nodular thickening of lymphatic vessels along limbs, pus and lymphocutaneous lesions

What kind of fungus is coccicoides immitis
Dimorphic fungus
Mould and yeast form of coccicoides immitis
Mould - septate hyphae which fragment into arthroconidia with arthrospores
Yeast - mature spherules are filled with endospores and are found in tissues

Clinical signs of coccicoides immitis
Cough, skin lesions, nasal granulomas, pulmonary and cutaneous forms

What kind of fungus is sporothric schenckii
Dimorphic fungus
Mould and yeast form of sprotothric schenckii
Mould - septate hyphae with conidiophores bearing conidia
Yeast - cigar shaped pleomorphic budding yeast cells

Clinical signs of sporothric schenckii
Horses have yellow discharge and subcutaneous edemas
Cats will have nodular skin lesions on face, tail, limbs
Dogs will have crusted alopecic lesions over head and trunk

What is aflatoxicosis caused by
Aflatoxin B1
Clinical signs of aflatoxicosis
Ataxia, tremors, hepatopathy

What is mycotoxic leukoencephalomalacia caused by
Fumonisin B1
What does mycotoxic leukoencephalomalacia affect
horses, donkeys and mules
Clinical signs of mycotoxic leukoencephalomalacia
difficulty swallowing, circling, staggering, blindness, depression, sudden death
What is porcine pulmonary edema caused by
Fumonisin B1
Clinical signs of porcine pulmonary edema
Laboured breathing, cyanosis, weakness, abortions
What is ergotism caused by
Ergotamine
What does ergotism cause
Gangrene of ears, tail and hooves
Lameness, cold extremities

What is facial ezcema caused by
Sporidesmin
What does sporidesmin do
Red swollen crusted skin on light coloured areas

What causes mycotoxic oestrogenism
Zearalenone
Clinical signs of mycotoxic oestrogenism
Vulvar swelling, redness, elargement, prolapse, infertility

What causes tremorgenic mycotoxicosis
Penitrem A
Clinical signs of tremorgenic mycotoxicosis
Tremors, rigidity, seizures, collapse, fainting
Morphology of staphylococcus

What causes staphyloccoccal mastitis
Staphylococcus aureus
What causes staphylococcal dermatitis
Staphylococcus aureus and staphylococcus pseudointermedius
Clinical signs of staphylococcal dermatitis
Pustules, crusts, alopecia, redness, itching

What causes greasy pig disease
Staphylococcus hyicus
Clinical signs of greasy pig disease
greasy lesions of face, ears, body
Crusts dehydration, death

Staphylococcus hemolysis
Aureus - beta
Pseudointermedius - beta
Hricus - no
Biochemical tests staphylococcus
Catalase - BUBBLES → positive
Oxidase - no colour change → negative
Morphology strepcoccocus

Which 3 streptococcus cause bovine streptococcal mastitis
Strep agalatiae, strep dysgalactiae, strep uberis
What is strangles caused by
Streptococcus equi
Strangles clinical signs
Discharge of URT, abseccesion of head and neck lymph nodes

What is porcine streptococcosis caused by
Strep suis
Clinical signs streptococcus suis
Meningitis, tilted head, convulsions, arthritis, abortions, endocarditis, pneumonia

Clinical signs streptococcus canis
Skin and soft tissue infections, septicemia, pneumonia…
Streptococcus biochemical tests
CAMP for agalactiae
Catalase negative → no bubbles
Is mycobacterium gram positive or negative
Cytochemically positive but doesnt stain well
What causes bovine tuberculosis
Mycobacterium bovis
Mycobacterium bovis clinical signs
Nodular lesions, often white and calcified
contain necrosis and macrophages

What is paratuberculosis caused by
Mycobacterium avium subsp paratuberculosis
Clinical signs of paratuberculosis
Enteritis, thickened mucosa, malabsorption, diarrhea, weight loss

What is tuberculin skin test for
Mycobacterium bovis
Corynebacterium morphology

What does corynebacterium bovis cause
Subclinical mastitis
What causes pseudotuberculosis
Corynebacterium pseudotuberculosis
Pseudotuberculosis clinical signs
Abscess in lymph nodes and internal organs

How is c. pseudotuberculosis transmitted
Transmitted via pus, oral/nasal discharge, coughing, vectors
What does corynebacterium renale cause
UTI in cattle, cystisis, pyeloneprhitis

What does rhodoccocus equi affect
foals
What does rhodoccocus equi cause
Bronchopneumonia, abcesses

Rhodococcus morphology

Culture of rhodococcus
Pink mucoid colonies on blood agar, non hemolytic
Nocardia morphology
Filamentous branching rods

Clinical signs nocardia
Pyogranulomatous infections (cutaneous, pulmonary or disseminated)
Chronic mastitis in cows, abortions in pigs

Nocardia staining
Modified ziehl neelson positive
What does arcanobacteria pyogenes cause
suppurative lesions in cows, sheep and pigs

What does actinobaculum suis cause
Urinary infections in pigs

What does actinomyces bovis cause
Lumpy jaw in cows

What does actinomyces viscosus cause
Subcutanoeus abcesses in dogs

What does dermatophilus congolensis cause
lumpy wool in sheep and strawberry footrot in cattle

Dermatophilus morphology
Filamentous branching rods with zoospores

Listeria morphology

What does listeria monocytogenes cause
Abortions, septicemia, stiff necks, muscle aches

Listeria biochemical tests
catalase positive, camp positive
Erysipelothrix morphology

What does erysipelothrix rhusiopathiae cause
Swine erysipela
Swine erysipela clinical signs
Diamond shaped lesions, chronic endocarditis, arthritis
Bacillus morphology

What does bacillus anthracis cause
Anthrax
Anthrax clinical signs
Ulcers with necrotic centers
Bloated cadavers

What would you use to stain bacillus spores
MZN
Clostridium morphology
